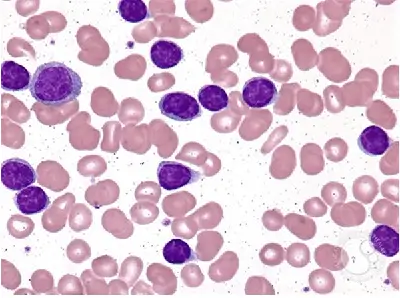
CLLの見通しはどうなりますか?

慢性リンパ性白血病 (CLL) は、白血球の一種である異常なリンパ球が骨髄で生成されることで発症する血液がんの一種です。異常なリンパ球は正常なリンパ球のようには機能しません。また、それらはより長く生存するため、体内に蓄積されます。
CLL の初期段階では、血液と骨髄内にリンパ球が多すぎますが、その他の白血病の兆候はありません。 CLL のこの段階では、多くの場合無症状であり、積極的な治療は必要ありません。
症状を引き起こしていない、または急速に進行している早期 CLL がある場合、医師はそれを管理するために注意深く待つことを推奨する場合があります。注意深く待っている間に積極的な治療を処方することはありませんが、状態を監視するために定期的な検査と血液検査をスケジュールします。
症状が進行する兆候が見られる場合、医師は 1 つまたは複数の治療法を処方することがあります。
治療の選択肢と早期 CLL の見通しについて詳しく知りたい方は、以下をお読みください。

早期CLLとは何ですか?
CLL と診断された場合、医師は症状がどの程度進行しているかを調べるために病期分類検査を指示します。
ステージ 0 は CLL の最も初期のステージです。この段階では、骨髄と血液中にリンパ球が多すぎますが、その他の白血病の兆候はありません。
ステージ 0 では、多くの場合、症状が現れません。この段階では、異常なリンパ球の再生が遅い傾向があるため、治療を行わなければ何年も状態が安定した状態が続く可能性があります。
CLL は最終的に、症状を引き起こし治療が必要となるさらに進行した段階に進行する可能性があります。
この場合、異常なリンパ球がより急速に増殖し始め、リンパ節、脾臓、肝臓などの他の領域に広がる可能性があります。血小板や赤血球など、他の種類の血球が入る余地が少なくなる可能性があります。これにより、感染症、貧血、不正出血のリスクが高まります。
CLL の各段階について詳しくは、以下をご覧ください。
| ステージ0 | • リンパ球が多すぎます。 • 他に白血病の兆候はない。 |
|---|---|
| ステージ1 | • リンパ球が多すぎます。 • リンパ節が通常より大きい。 |
| ステージ2 | • リンパ球が多すぎます。 • 肝臓または脾臓が通常より大きい。 • リンパ節が通常より大きい可能性があります。 |
| ステージ3 | • リンパ球が多すぎて、赤血球が少なすぎます。 • リンパ節、肝臓、脾臓が通常より大きくなっている可能性があります。 |
| ステージ4 | • リンパ球が多すぎて、血小板が少なすぎます。 • 赤血球が少なすぎる可能性があります。 • リンパ節、肝臓、脾臓が通常より大きくなっている可能性があります。 |
あなたの状態の段階について詳しく知るために医師に相談してください。

早期CLLの治療法は何ですか?
早期の CLL の場合、医師は注意深く様子を見て対処してくれる可能性があります。これは、アクティブ監視または監視待機アプローチとも呼ばれます。
この期間中、医師は積極的な治療法を処方しませんが、症状が進行しているかどうかを知るために定期的な検査と血液検査をスケジュールします。健康状態に変化があった場合は、そのことを知らせてください。
注意深く待っていることに緊張したり、治療を始めたいと思ったりするかもしれません。
しかし、白血病・リンパ腫協会によると、CLLがゆっくりと増殖し、症状を引き起こさない場合にCLLを治療(化学療法などの治療法で)することの潜在的なリスクと副作用は、一般に潜在的な利益を上回ります。
治療を開始するのが早すぎると、長期的な見通しが改善されずに副作用や合併症が発生する可能性があります。また、CLL の後期段階の治療に役立つ薬剤に対して身体が耐性を持つ可能性もあります。
CLLが進行するまで治療の開始を待つことで、長期的な見通しに悪影響を与えることなく、より高い生活の質をより長く維持できる可能性があります。
初期の CLL の管理について詳しくは、医師に相談してください。

CLL が進行している兆候は何ですか?
たとえそれが CLL に関連しているかどうかわからない場合でも、健康状態の変化に気付いた場合は医師に知らせてください。
以下の症状のいずれかは、CLL の進行を示している可能性があります。
- 首、脇の下、腹部、または鼠径部のリンパ節の腫れ
- 点状出血として知られる、皮膚の下の小さな暗赤色の斑点
- 出血しやすい、またはあざができやすい
- 肋骨の下の痛みや膨満感
- 疲労、倦怠感、または脱力感
- 原因不明の体重減少
- 寝汗
- 感染症
- 熱
医師は、CLL または別の疾患が症状の原因であるかどうかを理解するのに役立ちます。
血液細胞の変化をチェックするために定期的な血液検査を指示し、分析のために骨髄のサンプルを収集する場合もあります。
血小板レベルの低下、赤血球レベルの低下、血液または骨髄中のリンパ球数の突然の増加も、CLL が進行している可能性のある兆候です。
医師は、異常な血球が骨髄や血液から他の臓器に広がっているかどうかを調べるために画像検査を指示する場合があります。
さらに、脾臓、肝臓、リンパ節が腫れている場合は、CLL が進行しています。

治療の次のステップは何ですか?
CLL が症状を引き起こし始めた場合、または進行の兆候が見られた場合、医師は次の 1 つまたは複数による治療を推奨する場合があります。
- 放射線治療
- 次のような薬:
- 標的療法
- 化学療法
- 免疫療法
- 幹細胞移植
同種幹細胞移植はCLLの唯一の治療法であるが、この治療法には重篤な副作用が発生するリスクが高い。代わりに、医師はあなたの状態を管理するために、よりリスクの低い治療法を推奨する場合があります。
場合によっては、症状が現れ始めた後、医師が一定期間注意深く待つことを推奨する場合があります。
また、症状が現れるとすぐに治療を処方する場合もあります。
以下の場合、医師は治療の変更を勧める場合があります。
- あなたの状態は進行の兆候を示しているか、急速に進行しています
- あなたの状態は一定期間安定した後、再び進行し始めています
- 現在の治療は管理が難しい副作用を引き起こしています
- 全体的な健康状態、治療目標、または好みが変化した場合
- 新しい治療法が利用可能になりました
医師は、症状が安定した場合には治療を一時停止し、再び活動性が高まる兆候が見られた場合には治療を再開することがあります。 CLL 患者の多くは、複数年にわたって断続的な治療を受けます。
医師は、感染症のリスクを管理するために、特定のワクチン接種、予防薬、またはライフスタイル戦略を推奨する場合もあります。感染症の早期治療も重要です。
医師は治療を推奨する際に複数の要素を考慮します。
CLLの見通しはどうなりますか?
CLL は治癒することはほとんどありませんが、この状態で何年も生きる可能性があります。
米国癌協会は、CLL の 5 年相対生存率は次のように報告しています。
CLL 患者の中には、他の人よりも生存率が高い人もいます。
具体的な見通しは、次のようないくつかの要因によって決まります。
- あなたの年齢と全体的な健康状態
- 異常なリンパ球がどのくらいの速さで増加するか
- 異常なリンパ球が広がっているかどうか
- 異常なリンパ球に特定の遺伝子変異があるかどうか
- あなたが受けた治療とあなたの体がそれに対してどのように反応するか
早期CLL患者の中には、診断から最初の数年以内に症状が現れて治療が必要になる人もいますが、症状が出ず、治療も必要とせずに何年も生きる人もいます。
2020年の研究では、特定の危険因子にもよりますが、早期CLL患者の約8~62%が5年以内に治療が必要であることがわかりました。特定の遺伝子変異の検査結果が陽性となる異常なリンパ球がある場合は、5 年以内に治療が必要になる可能性が高くなります。
CLL は、びまん性 B 細胞リンパ腫などの進行性のリンパ腫に変化することがあります。これはリヒター変換またはリヒター症候群として知られています。 CLL患者の2~10%が罹患しています。
医師は、治療の選択肢と CLL の見通しについて詳しく知るお手伝いをします。

持ち帰り
CLL は、血液および骨髄内に異常なリンパ球を蓄積させます。
CLL の初期段階では通常、症状が現れず、積極的な治療は必要ありません。医師は、定期的な診察や血液検査を行って状態を監視する、慎重に待つことを勧めるでしょう。
多くの人は、症状を発現したり治療を必要とせずに、初期の CLL を何年も抱えて暮らしています。
症状が現れた場合、または検査で CLL の進行が示された場合、医師は治療を勧める場合があります。
医師に相談して、自分の状態、治療の選択肢、見通しについて詳しく知ることができます。
参考文献
- https://ashpublications.org/blood/article/135/21/1859/454292/International-prognostic-score-for-asymptomatic
- https://www.lls.org/leukemia/chronic-lymphocytic-leukemia/treatment/complications-cll-or-cll-treatment
- https://www.cancer.org/content/dam/cancer-org/research/cancer-facts-and-statistics/annual-cancer-facts-and-figures/2023/2023-cancer-facts-and-figures。 pdf
- https://www.lls.org/leukemia/chronic-lymphocytic-leukemia/treatment/watch-and-wait
初期慢性リンパ性白血病: 治療の選択肢を知る・関連動画
免責事項: 健康百科事典ブログは、すべての情報が事実に基づき、包括的で最新のものであるよう努めています。しかし、この記事は、資格を持つ医療専門家の知識や専門性の代替として使用されるべきではありません。薬を服用する前には、必ず医師または他の医療専門家に相談してください。ここに記載されている情報は変更される可能性があり、すべての可能な用途、指示、注意事項、警告、薬物相互作用、アレルギー反応、副作用を網羅することを意図しているわけではありません。特定の薬物または薬物の組み合わせに関する警告や情報が記載されていない場合でも、その薬物や組み合わせがすべての患者やすべての用途において安全、有効、適切であることを意味するものではありません。
